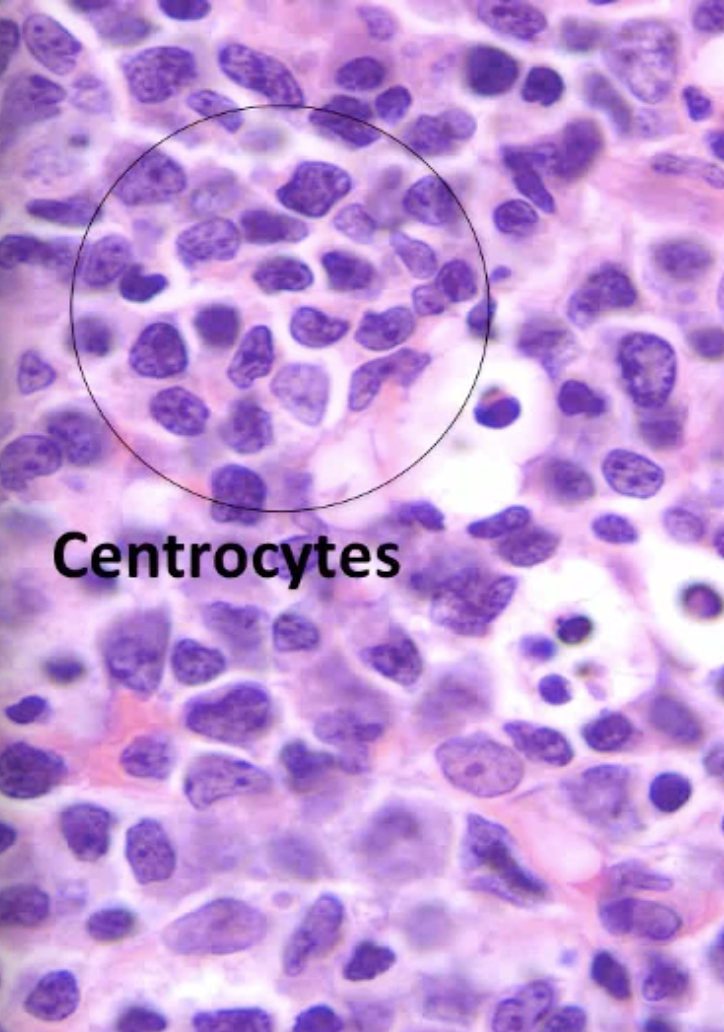
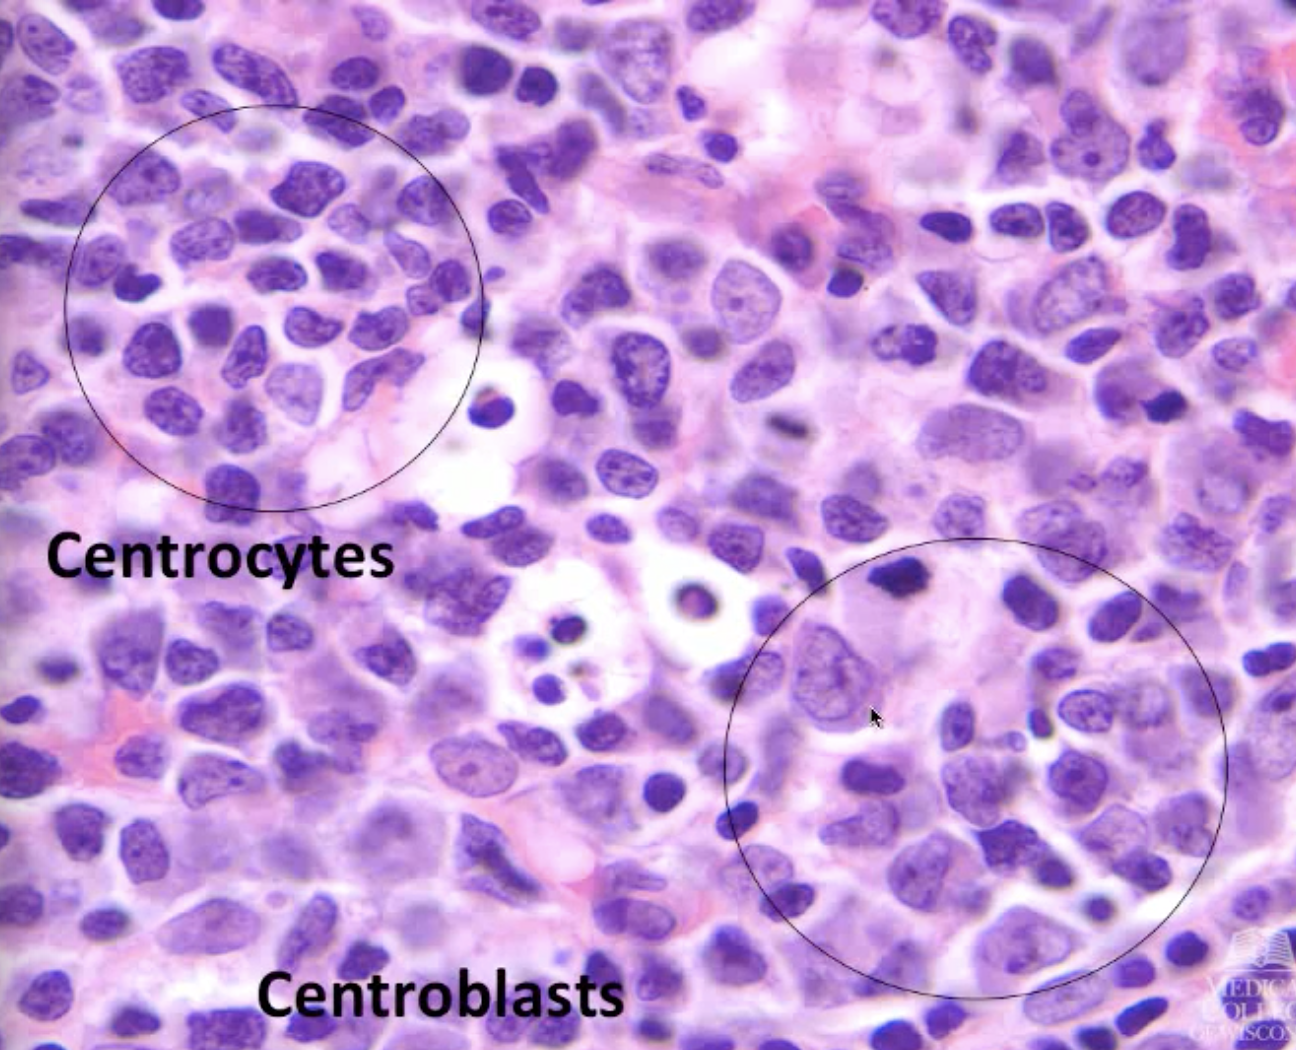
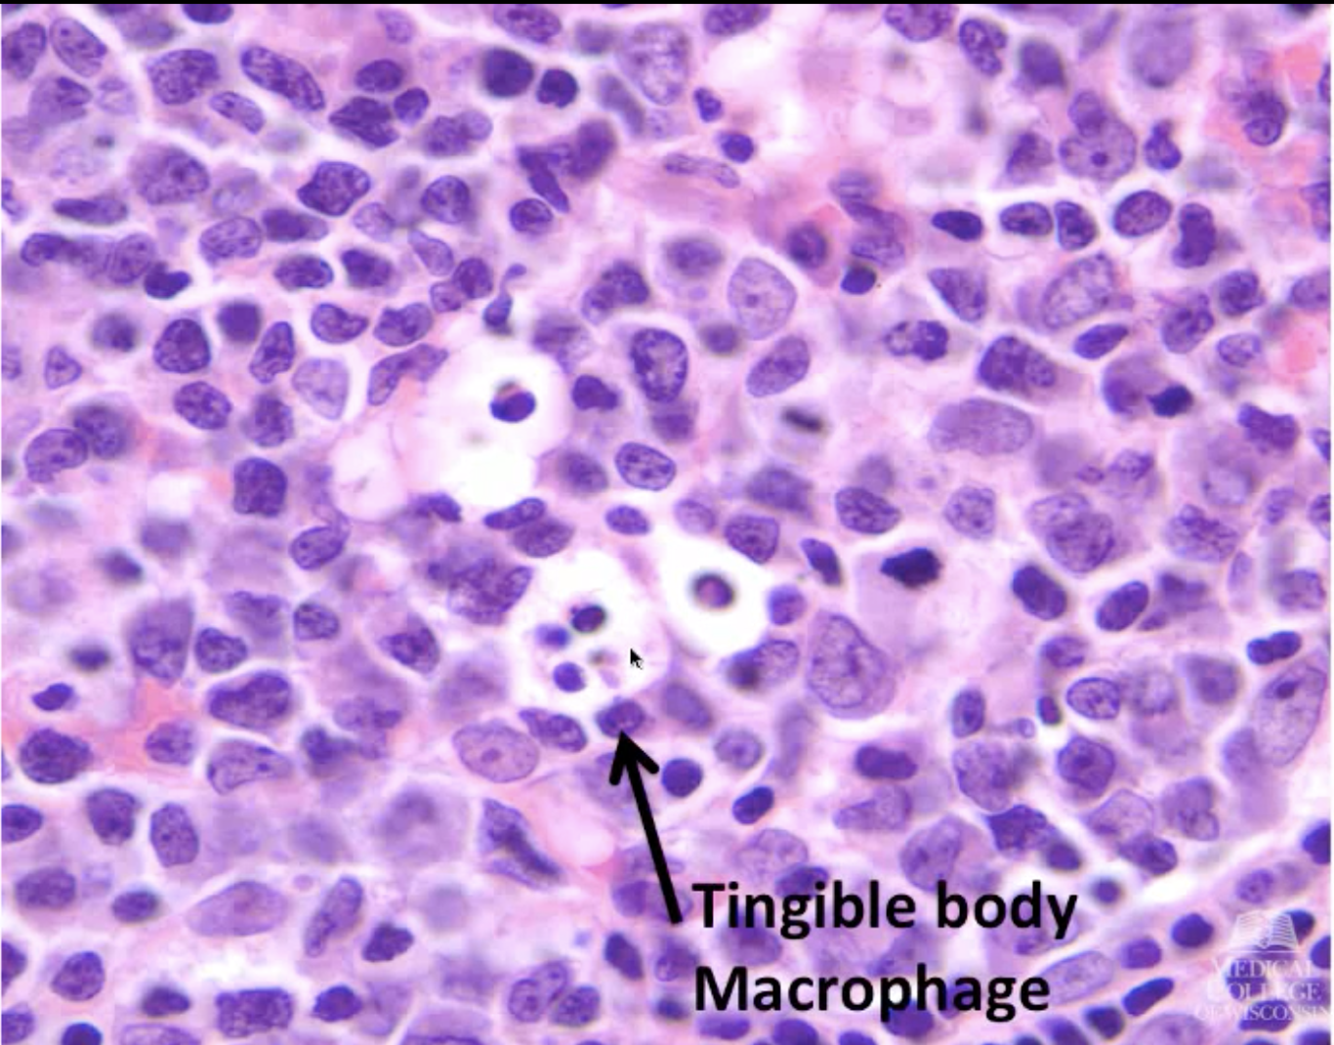
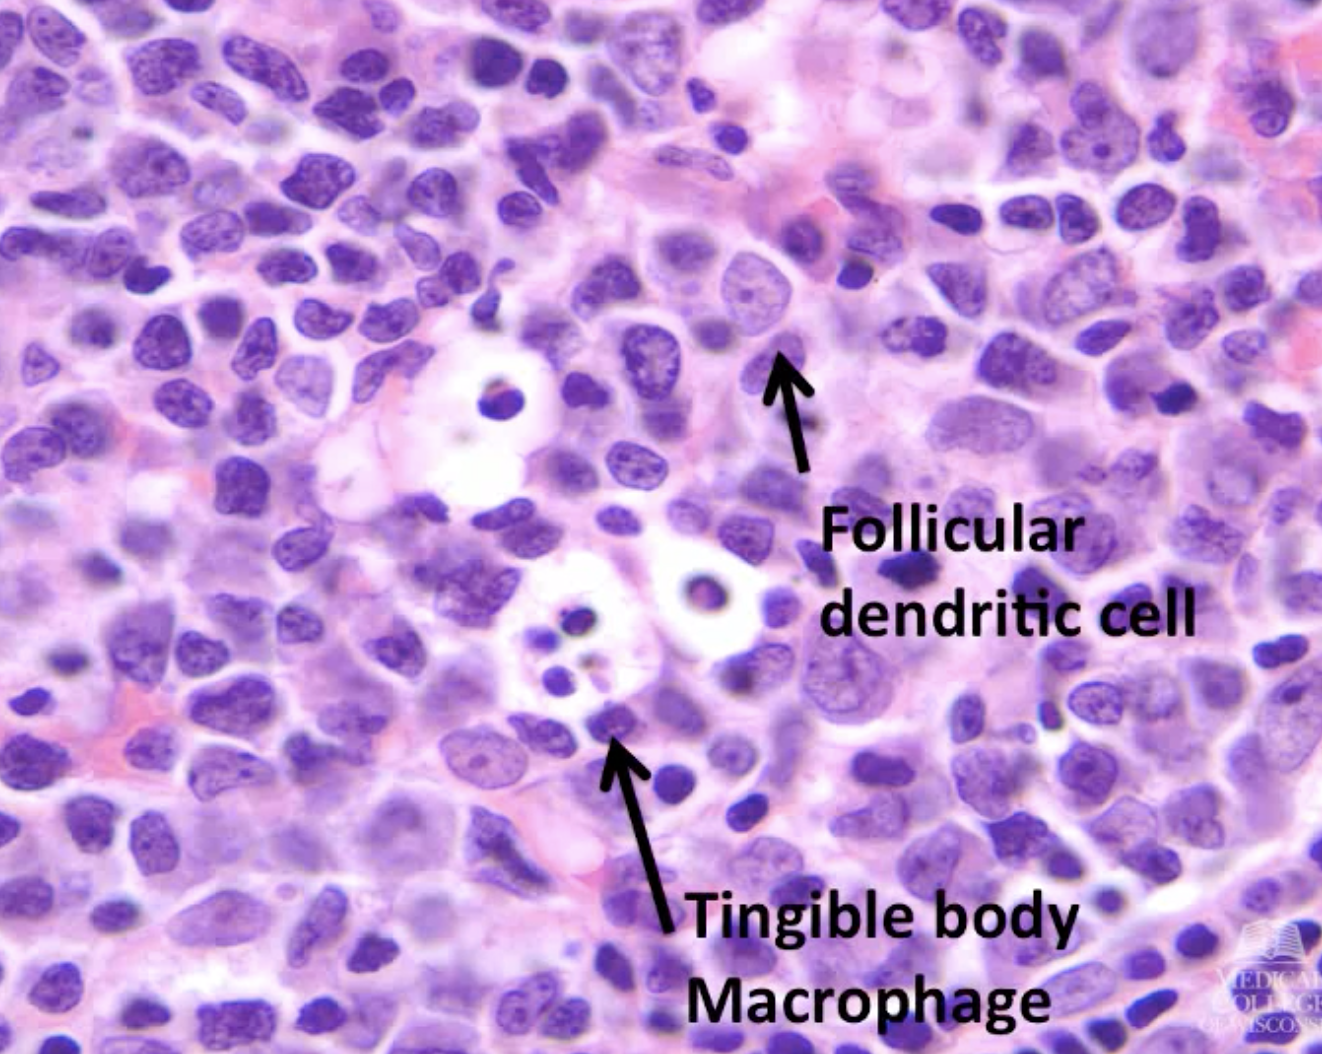
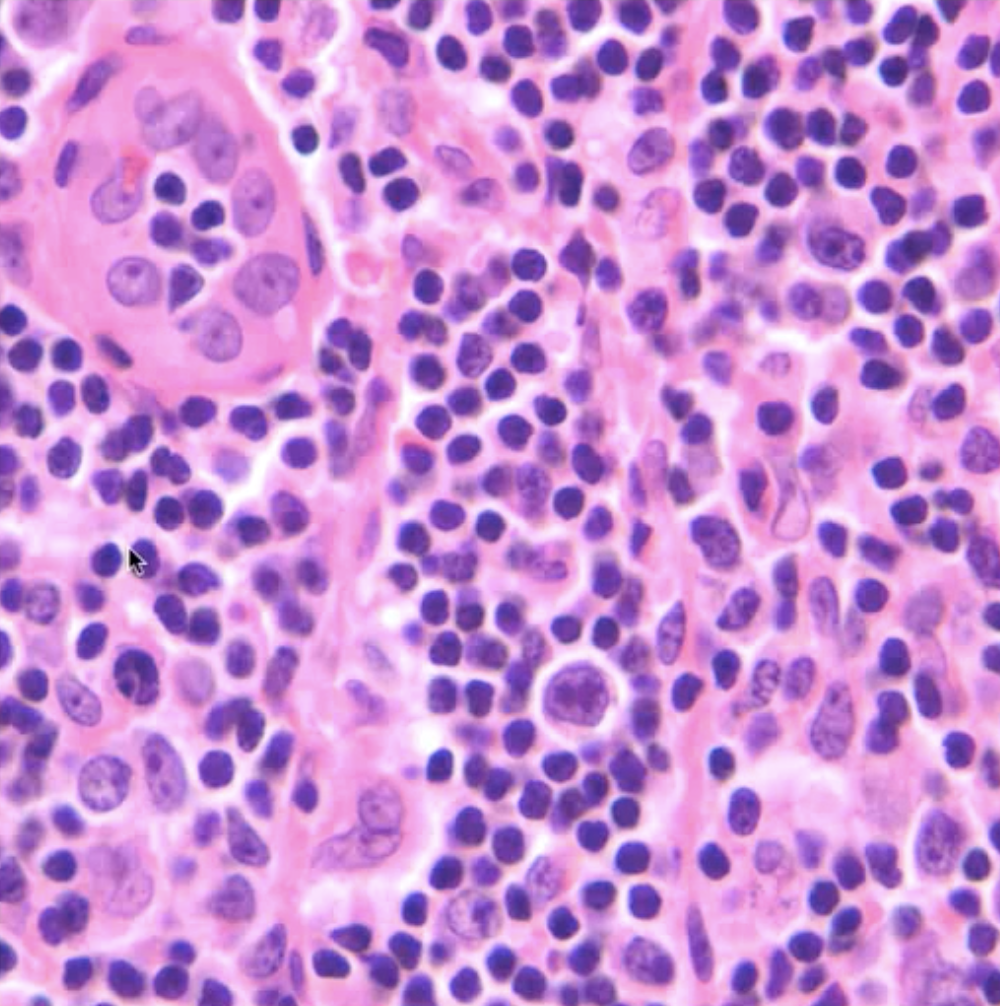
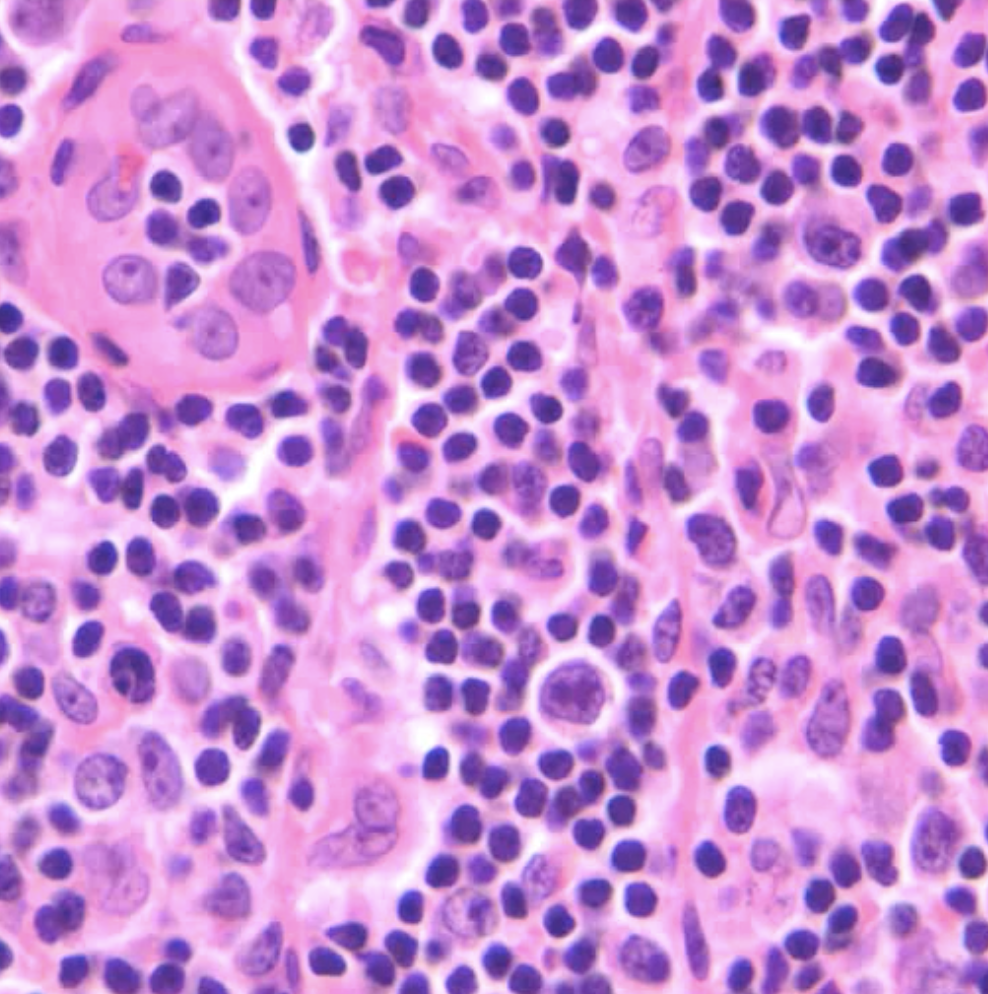

How does lymph get to and from the lymph node? How do the contents of the two vary?
It enters through the afferent lymphatics and leaves through the efferent lymphatics.
The lymph in the efferent lymphatics have more lymphocytes that have been picked up during its time in the node.

What is the subcapsular sinus?
A space in the lymph node that lies below the thin fibrous capsule and is created by thin walled endothelial cells. .
This dives into the cortex and gives rise to cortical sinuses that give rise to medullary sinuses.
Lymphocytes and macrophages are seen in the sinus in this image.

What do you need to see in a lymph node for it to be considered intact?
Paracortex and follicles.
Most benign nodes have intact architecture, most malignant nodes have disturbed architecture.

What are follicular structures? What occurs in the paracortex?
Where B cell development occurs.
Paracortex contains a predominance of T cells and is very vascular.

What are the zones of the follicle and what happens in each zone?
Germinal center: where B cell development occurs; freq where they encounter antigen and proliferate in response to antigen
Mantle zone: B cells reside here
Marginal zone: B cells reside here

Where are naive B cells located? What happens upon antigen presentation?
Naive: mantle zone.
Upon antigen presentation: B cells migrate to the germinal center. They are now ready to proliferate. Once they proliferate they can either migrate to the marginal zone and reside there OR go to the blood to have its effect.

What is the purpose of the light and dark zone in the lymph node?
Light zone: smaller cells that are less proliferative and are not completely antigen stimulated.
Dark zone: larger cells with more dispersed chromatin, more proliferative.
This causes follicles to have polarity! Polarized follicles indicate a normal reactive process.

What are centrocytes and where are they located?
In the light zone of the germinal center.
Smaller cells with coarse chromatin and irregular nuclei.
What are centroblasts and where are they located?
In the dark zone of the germinal center.
They have much more open and delicate chromatin (less purple). They are 2-3x the size of centrocytes.
What are tingible body macrophages?
Macrophages with debris in them within reactive lymph follicles.
Present when there’s cell turnover/prolif. As centrocytes become centroblasts, there is cell turnover and death and macrophages clean up the mess.
What is the function of dendritic cells in the follicle?
They form the framework or stromal meshwork of the germinal center/follicle.
What are characteristics of the paracortex?
What is the structure of high endothelial venules? What is its function?
They are lined with plump cuboidal endothelial cells.
They are the major site of entry of lymphocytes into the parenchyma of the lymph node.
It has adhesion molecules that facilitate this function.

What is in the upper left hand corner of this image?
A high endothelial venule.
What is an immunoblast?
Large, activated T cells with more dispersed chromatin and large prominant nucleoli and variably vaculated cytoplasm.
They are activated helper T cells that may remain in the paracortex OR leave the node through the efferent lymphatics for effector functions.
**in this image it is in the middle but slightly down and left. Larger cell tham the lymphocytes around it**
The majority of the splenic parenchyma consists of ____ pulp. What occurs here?
Red pulp. Filtering of RBCs and blood.
(White pulp is where immune effect occurs.)

What is the function of the white pulp of the spleen? What are the two regions of the white pulp?
Functions as the immune system (lymphoid tissue)
T cell rich areas: periarteriolar lymphoid sheath (PALS)
B cell rich areas: follicles
How does the histology of a normal spleen differ from that of lymphoma?
Normal: architecture maintained; see white and red pulp.
Lymphoma: big nodules of what looks like white pulp (purple), obliteration of architecture.

Where is mucosa-associated lymphoid tissue found and what is its function?
GI tract, resp tract, oral mucosa, and ductal mucosa (salivary, breast, etc.)
Filters luminal (gut, ducts, cavities) contents and carries to regional lymph nodes via efferent lymphatics.